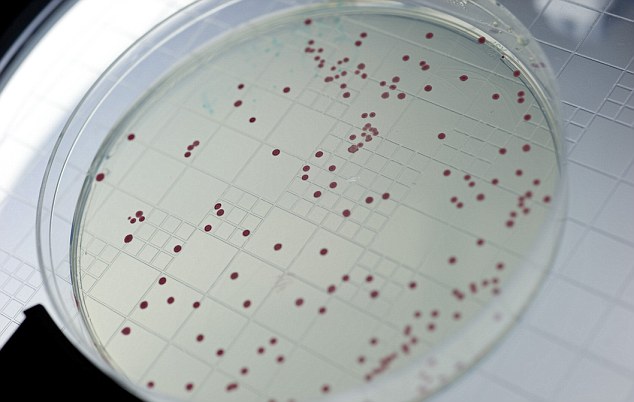

Sejenis bakteria yang berusia 500 juta tahun telah dibawa balik ke dalam sebuah makmal di Georgia Tech untuk dihidupkan semula. Gen daripada bakteria 'kuno' ini kemudiannya telah digabungkan bersama ke dalam sejenis bakteria moden masa kini iaitu E Coli.
Bakteria ini telah berkembang dengan pesat dan telah mula mencapai ke tahap 1,000 generasi semasa berada di dalam makmal. Para saintis yang mengkaji mengenai bakteria 'kuno' ini berharap untuk mengetahui sama ada ia akan berkembang dengan cara nya yang tersendiri pada suatu ketika dahulu atau ia akan berevolusi dan berkembang untuk menjadi organisma yang baru.
"Ini merupakan suatu penemuan yang sangat hampir yang dapat kami jalankan untuk memutar kembali pita molekul hidup," ujar Betül Kaçar, seorang saintis dan astrobiologist NASA di Georgia Tech.
Bakteria ini mula bermutasi dengan pantas dan ada yang telah mula menjadi lebih kuat dan sihat daripada kuman yang sedia ada pada hari ini.
Bakteria ini telah berkembang dengan pesat dan telah mula mencapai ke tahap 1,000 generasi semasa berada di dalam makmal. Para saintis yang mengkaji mengenai bakteria 'kuno' ini berharap untuk mengetahui sama ada ia akan berkembang dengan cara nya yang tersendiri pada suatu ketika dahulu atau ia akan berevolusi dan berkembang untuk menjadi organisma yang baru.
"Ini merupakan suatu penemuan yang sangat hampir yang dapat kami jalankan untuk memutar kembali pita molekul hidup," ujar Betül Kaçar, seorang saintis dan astrobiologist NASA di Georgia Tech.
Bakteria ini mula bermutasi dengan pantas dan ada yang telah mula menjadi lebih kuat dan sihat daripada kuman yang sedia ada pada hari ini.
"Keupayaan untuk mengkaji gen bakteria 'kuno' di dalam organisma moden memandangkan ia mampu berkembang di dalam sel yang moden membolehkan kami untuk menilai sama ada trajektori evolusi yang telah berlaku sekali dahulu mampu untuk berulang semula pada bakteria ini atau sama ada ia akan menyesuaikan diri nya di dalam persekitaran yang berlainan."
"Organisma yang telah diubah tidak lah sesihat mana, sekurang-kurangnya pada tempoh permulaan," ujar Gaucher lagi. Walaubagaimana pun, ia mampu mewujudkan satu senario yang sempurna di mana bakteria yang telah diubah secara genetik ini boleh menyesuaikan diri dan menjadi lebih kuat akibat sering bermutasi dengan persekitaran sekeliling saban hari.
Kadar pertumbuhan bakteria ini dijangka akan terus meningkat dan selepas 500 generasi pertama, para saintis akan menyusun semula mengikut urutan genom bagi menentukan bagaimana bakteria ini menyesuaikan diri.
Walaubagaimanapun, gen bakteria purba ini masih belum mampu untuk bermutasi menjadi sebuah bakteria yang merbahaya sebaliknya hanya menemui cara untuk menyesuaikan diri di dalam persekitaran yang baru ini.
"Organisma yang telah diubah tidak lah sesihat mana, sekurang-kurangnya pada tempoh permulaan," ujar Gaucher lagi. Walaubagaimana pun, ia mampu mewujudkan satu senario yang sempurna di mana bakteria yang telah diubah secara genetik ini boleh menyesuaikan diri dan menjadi lebih kuat akibat sering bermutasi dengan persekitaran sekeliling saban hari.
Kadar pertumbuhan bakteria ini dijangka akan terus meningkat dan selepas 500 generasi pertama, para saintis akan menyusun semula mengikut urutan genom bagi menentukan bagaimana bakteria ini menyesuaikan diri.
Walaubagaimanapun, gen bakteria purba ini masih belum mampu untuk bermutasi menjadi sebuah bakteria yang merbahaya sebaliknya hanya menemui cara untuk menyesuaikan diri di dalam persekitaran yang baru ini.
Hasil keputusan kajian ini telah dibentangkan Persidangan Antarabangsa Sains Astrobiology NASA baru-baru ini. Para saintis dijangka akan mempelajari sesuatu mengenai protein di dalam bakteria ini sama ada ia akan mengikut jejak langkah nya yang lampau atau menyesuaikan diri di dalam dunia yang serba baru.
"Kami jangka bahawa proses ini akan membolehkan kami menjawab beberapa persoalan yang telah lama wujud berkaitan dalam biologi evolusi dan molekul." kata Kaçar lagi.
Antaranya, kita mahu tahu sekiranya sejarah organisma mampu mengehadkan kemampuannya di masa hadapan dan sekiranya proses evolusi mampu memberi penyelesaian kepada masalah yang diberikan.
"Kami jangka bahawa proses ini akan membolehkan kami menjawab beberapa persoalan yang telah lama wujud berkaitan dalam biologi evolusi dan molekul." kata Kaçar lagi.
Antaranya, kita mahu tahu sekiranya sejarah organisma mampu mengehadkan kemampuannya di masa hadapan dan sekiranya proses evolusi mampu memberi penyelesaian kepada masalah yang diberikan.
Sumber : Here

16 comments:
Assalamualaikum
Walaikumussalam.
calling-calling my hp number 017-3309311 is mel bercakap.
Wa'laikomsalam...
satu lagi senjata biologi yahudi tercipta.
dengan izin Allah sahaja manusia mampu melakukan sesuatu perkara..
sya sedikit x phm ,, untuk ape..memutarkan kembali molekul hidup ..??
molekul dihidupkan untuk menhancurkan bumi... huahuahua...
geli aku tengok kuman tu.rasa mcm melekat kat tangan aku
kuman yg comel
betol ke @ mereka mencipta sesuatu yg baru???herm.....----->kakcik
bakteria terlepas smua brtukar jd zombie.haha
Appocolip la pas ni..keh3
hebat yah,,,bisa jadi seperti itu...terima kasih untuk informasinya
sume jdk zombie
buat penyakit baru... then sebarkan.. b4 that ubat tuk penyakit tu dah ada n simpan senyap2... dah kes teruk... buat2 analisis... then kata dah jumpa penawar.. then jual... then kaya raya...
Post a Comment